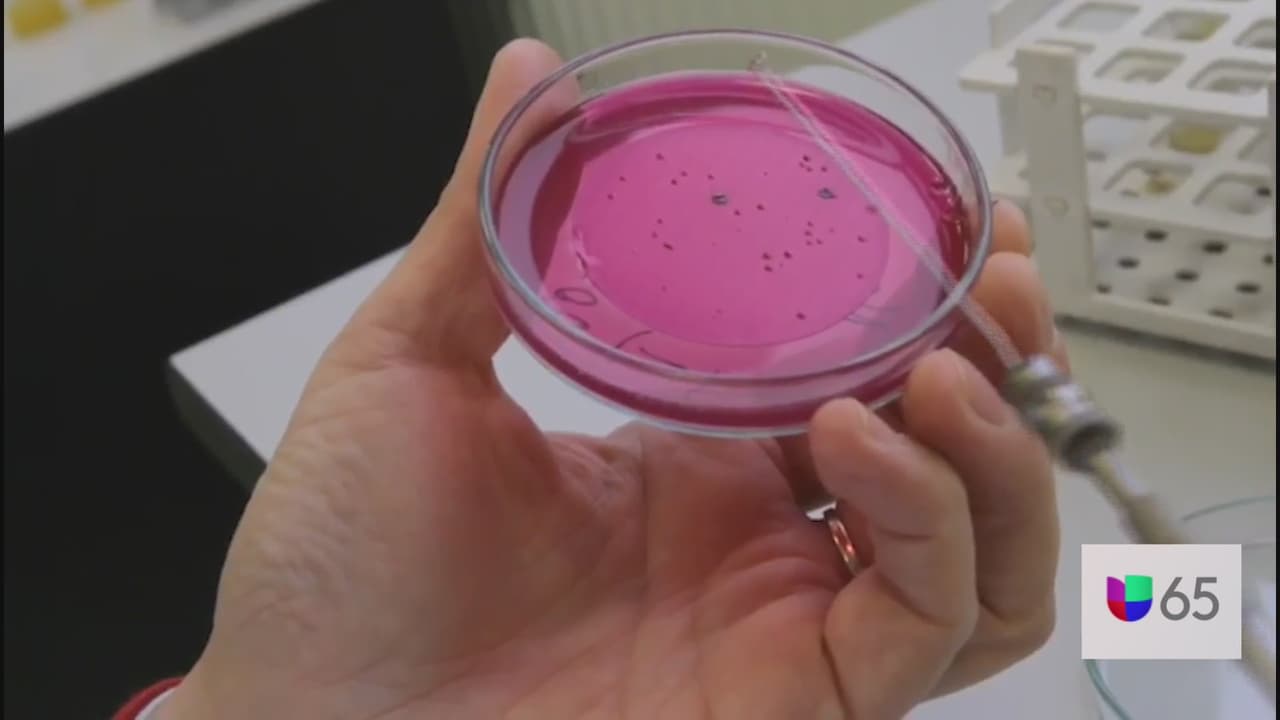
<b>¿Por qué la ciudad recomienda de nuevo el enmascaramiento en interiores? </b>Los funcionarios de salud de Filadelfia recomiendan el enmascaramiento en interiores porque la 
<a href="https://www.univision.com/local/philadelphia-wuvp/dosis-refuerzo-protegerme-variante-delta-coronavirus">variante delta</a> altamente contagiosa ha provocado un aumento en los casos de COVID-19 entre las personas no vacunadas.

FILADELFIA, PA- La principal funcionaria de salud de Filadelfia dice que no hay planes a partir de ahora para levantar el mandato de máscara que la ciudad ha estado bajo desde agosto.
El mandato de mascarilla se mantendrá indefinidamente en Filadelfia
Ciertos negocios esenciales como tiendas de abarrotes, farmacias, consultorios médicos y servicios de urgencias no pueden utilizar la única excepción de vacunados al mandato de la mascarilla. La comisionada Bettigole dijo que las hospitalizaciones son aproximadamente tres veces más altas que durante del verano. Las tasas de casos son aproximadamente cuatro veces más altas.

"No hay un número que veamos. Es una combinación", dijo a los informes la comisionada de salud interina, la Dra. Cheryl Bettigole, durante una sesión informativa sobre Zoom el miércoles. "Tasas de casos, tasas de hospitalización, así como lo que sucede a nuestro alrededor".
El último mandato de máscara de la ciudad entró en vigor el 12 de agosto debido al aumento de la variante delta. Según el mandato, las máscaras deben usarse en negocios que no requieren que todos los que ingresen estén vacunados.
Ciertos negocios esenciales como tiendas de abarrotes, farmacias, consultorios médicos y servicios de urgencias no pueden utilizar la única excepción de vacunados al mandato de la mascarilla.
Bettigole dijo que las hospitalizaciones son aproximadamente tres veces más altas que durante del verano. Las tasas de casos son aproximadamente cuatro veces más altas.
Ella dijo que los condados circundantes tienen tasas de vacunación muy altas, pero tasas de casos y tasas de positividad más altas que Filadelfia.
"Es un poco preocupante porque no tiene del todo sentido", dijo Bettigole. "La única diferencia real es el mandato de la máscara".
Pensilvania levantó su mandato de mascarilla universal el 28 de junio. En septiembre, el estado emitió un mandato de máscara para las escuelas K-12 y las guarderías.
"Creo que si está viendo si Filadelfia entra en esa zona de baja transmisión y las hospitalizaciones están muy bajas, y las cosas se ven bien a nuestro alrededor, ese sería un buen momento para deshacerse de eso", dijo Bettigole.
"Así que lo mantendremos en su lugar por ahora, pero, por supuesto, observaremos constantemente esos números para ver qué es factible".
Bettigole dice que atribuye tanto a las vacunas como a las máscaras los recuentos de minúsculas en Filadelfia.
"Todos estamos deseando que llegue el día en que no tengamos que usar máscaras dondequiera que vayamos", dijo Bettigole.